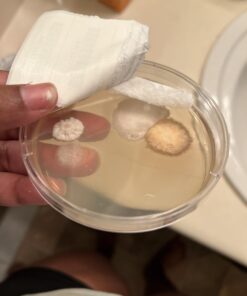
Mold Armor Do It Yourself Mold Test Kit 29 61KYEhFGstL
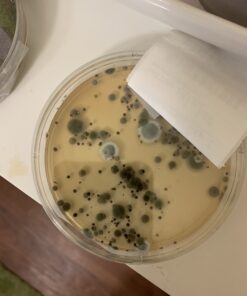
Mold Armor Do It Yourself Mold Test Kit 31 A1duiQXuRdL
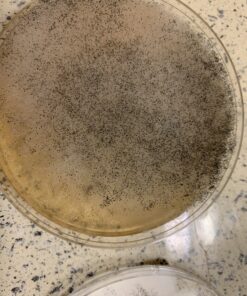
Mold Armor Do It Yourself Mold Test Kit 33 B1V qXDMbjS
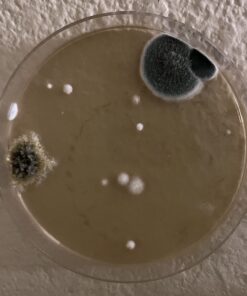
Mold Armor Do It Yourself Mold Test Kit 37 71av6AkCxiL
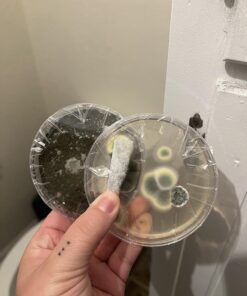
Mold Armor Do It Yourself Mold Test Kit 38 71BN5KbEB5L
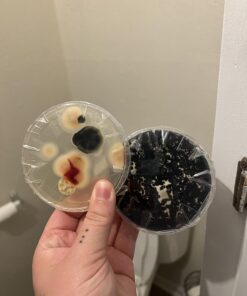
Mold Armor Do It Yourself Mold Test Kit 39 71LNCtfDmLL
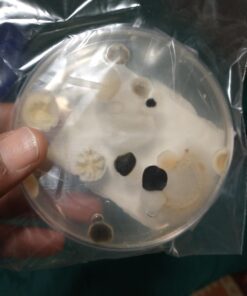
Mold Armor Do It Yourself Mold Test Kit 40 61Zo9rgl97L
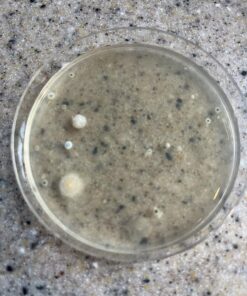
Mold Armor Do It Yourself Mold Test Kit 42 81ZZ5c0yEJL

Mold Armor Do It Yourself Mold Test Kit
Description
The MOLD ARMOR Do It Yourself Mold Test Kit will safely
and easily test for the presence of inside or outside mold with results within
48 hours. This convenient home kit also serves as an air quality monitor and
includes three testing methods: Indoor Air Quality Test Method, Air
Conditioning & Heating Sample Method, and a Surface Sampling Testing Method
when visible mold is present. This air quality test kit can also be used to
detect unseen mold in the home. Each kit contains a petri dish, swab, and mold
growth medium. This mold test kit also includes an option for mail-in lab
analysis to determine the mold type. While the MOLD ARMOR Do It Yourself Test
Kit can be an important part of protecting your family against mold, many
factors contribute to any test’s effectiveness. The mold test kit can only
detect airborne or surface mold spores, depending on test method, that are
present in the area during testing. If symptoms of mold exposure persist,
consult a certified mold specialist. Follow directions carefully and keep out
of reach of children. From the Manufacturer Now there is a fast, easy,
affordable and safe solution to fighting mold problems. Mold Armor is the
proven effective product line dedicated solely to finding, cleaning and
preventing mold and mildew stains on the inside and outside of your home.
Protect, renew and restore your home’s beauty with Mold Armor. Mold Blockers
prevent mold and mildew from growing for up to 2 months.
Features:
- Mold Armor FG500 Do It Yourself Mold Test Kit
- MOLD ARMOR Do It Yourself Mold Test kit safely and easily tests for the presence of mold with visible results in as little as 48 hours.
- The Do It Yourself Mold Test Kit can be used for indoor or outdoor mold testing. Tests indoor air quality for unseen mold in the home.
- There are three testing methods: (1) Indoor Air Quality Test Method (2) Air Conditioning & Heating Sample Method (3) Surface Sampling Testing Method (when visible mold is present).
- Each air quality tester and mold kit contains a petri dish, swab, and mold growth medium.
- This mold detection kit can be used to test surface molds or to take an air sampling from a building HVAC.
- The MOLD ARMOR Do It Yourself Mold Test kit is a safe and easy way to test for mold.
- Option for a mail-in lab analysis to determine the mold type.
- Offers three easy testing methods for indoor or outdoor mold testing and air quality testing.
- This Mold Test Kit tests for the presence of mold.
- Visible results in as little as 48 hours.
Product Details:
- Brand: Mold Armor
- Style: Test Kit
- Power Source: Solar Powered
- Color: Green
- Product Dimensions: 1.3"D x 5.1"W x 7"H
- Material: Paper
- Manufacturer: Mold Armor
- Part Number: FG500
- Item Weight: 2.39 ounces
- Product Dimensions: 1.37 x 5.12 x 7 inches
- Country of Origin: China
- Item model number: FG500
- Is Discontinued By Manufacturer: No
- Size: 1 Count (Pack of 1)
- Color: Green
- Style: Test Kit
- Material: Paper
- Power Source: Solar Powered
- Item Package Quantity: 1
- Number Of Pieces: 1
- Certification: Mold Armor FG500 Do It Yourself Mold Test Kit
- Included Components: Mold Armor FG500 Do It Yourself Mold Test Kit
- Batteries Included?: No
- Batteries Required?: No
- Date First Available: September 7, 2009

Reliance 9000429-045 Heavy Duty Heating Element Wrench
Emeril's Jazzed Up Decaf Coffee K-Cup Portion Pack For Keurig Brewers 24-Count
8 Tier Cascade Wedding Cake Stand (STYLE R800)
National Brand Computation Notebook, 4 X 4 Quad, Brown, Green Paper, 11.75 x 9.25 Inches, 75 Sheets (43648) 1
Paladone Legend of Zelda Hyrule Pen & Pen Topper
Vividsun Green Leaf Flower Crown Eucalyptus Crown Wedding Bridal Maternity Photo Props Headpiece A/Purple
VEVOR 5T 5Tiers Commercial Chocolate Fountain Machine 68cm/27inch Stainless Steel Auto Temperature Control 86-302? for Wedding Parties, 5 Tiers,
Ortho Snake B Gon Snake Repellent Granules, 2-Pound (Not Sold in AK) 2 Pound (Pack of 1)
Organic Edamame Spaghetti - 2 Lbs (907G)
Instant Read Digital Meat Thermometer - Ultra Fast Electronic BBQ and Kitchen Food Thermometer with long probe for Cooking, Grill, Smoker, Candy - Battery Included Blue
NADAMOO Wireless Barcode Scanner 328 Feet Transmission Distance USB Cordless 1D Laser Automatic Barcode Reader Handhold Bar Code Scanner with USB Receiver for Store, Supermarket, Warehouse
BBQ funland B5050 (Include Screws) Stainless Steel Heat Plate Brackets, Burner Hanger Brackets Replacement for Chargriller 5050 Duo, Chargriller 3001 (Set of 6)
Swingline Stapler, Light Duty Desktop Stapler, 20 Sheet Capacity, Black (S7040501) Pack of 1
Hongso SPA231 (4-Pack) Stainless Steel BBQ Gas Grill Heat Plate, Heat Shield, Heat Tent, Burner Cover, Vaporizor Bar, and Flavorizer Bar for Costco Kirland, Jenn-air, Nexgrill, Lowes (17 3/4 4-Pack
Bellemain Stainless Steel Measuring Cup Set, 6 Piece
Nertpow Winter Daily Beanie Hat for Men Women, Warm Fleece Lined Thermal Trendy Thick Knit Skull Cable Cuff Cap
Armory Replicas Spartan Life Size Historical Shield Aluminum Cast Aluminum Cast Spartan
LARACE Short Sleeve Shirts for Womens Plus Size Tops Casual Summer Clothes Asymmetrical Tunic Blouses Dark Green 1X
Splenda No Calorie Sweetener Value Pack 1200 Individual Packets 1200 Packets
Baby Gender Predictor Test Kit - Early Pregnancy Prenatal Sex Test - Predict if your baby is a boy or girl in less than a minute from the comfort of your home. Non-toxic and safe for you and your baby. Satisfaction GUARANTEED.
Kingston HyperX FURY Black 8GB 2133MHz DDR4 Non-ECC CL14 DIMM Desktop Memory (HX421C14FB/8) DDR4 2133MHz
iPearl mCover Hard Shell Case for 10.1-inch ASUS Chromebook Flip C100PA Series Laptop (Purple) Purple
Tune Belt Deluxe CD Player/Walkman Holder - Black
Ama_Trulystep MSC03 Copper Alcohol Moonshine Ethanol Still Spirits Boiler Distiller, 20 Litres